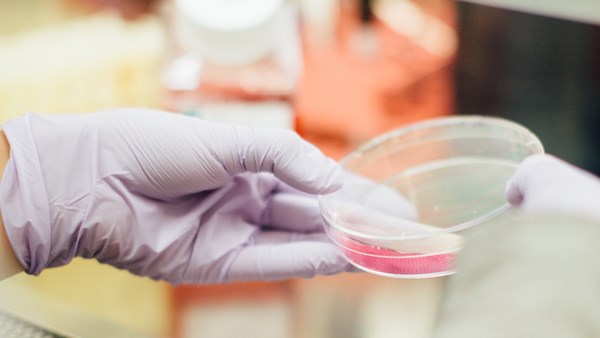

Back
Support SGC UK (and get involved)
Come along to one of our network meetings. Donate tissue to the Biobank to help drive forward research. Fundraise for us. Contribute to a patient - researcher trial discussion day. There are lots of ways to get involved.